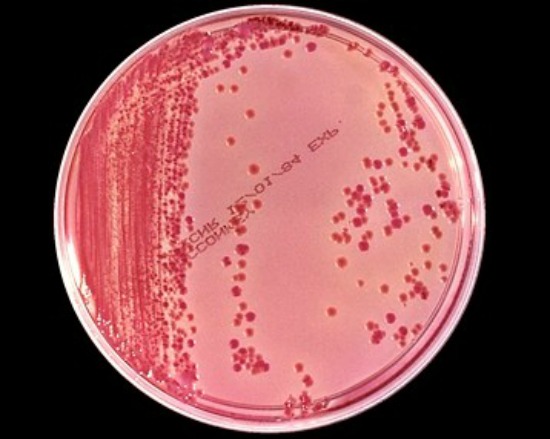
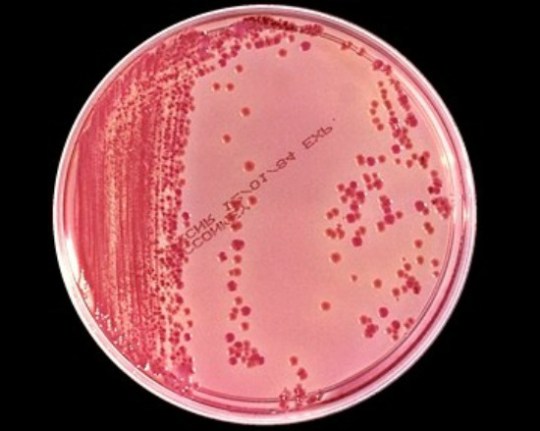
Image

A recent analysis of 10 studies showed that taking cinnamon supplements improved fasting blood glucose in people with diabetes. Here is a link to an article commenting on the study. I find that people appreciate incorporating these natural remedies into their treatment for chronic diseases. Another natural strategy I recommend to my patients is increasing their cherry intake to decrease their frequency of gout attacks. Here is an article reporting on the study that supports this treatment.
Monthly Archives: September 2013
Superbugs
The Centers for Disease Control and Prevention (CDC) recently released a “landmark” report on the rising and lethal threat of antibiotic resistance. CDC director Tom Frieden sounded the warning that “if we are not careful, we will soon be in a post-antibiotic era.” By this he means that infections we now routinely treat may someday not respond to antibiotics. In the following review of the book Superbug, I touch upon many of the issues addressed in the CDC report.
With its ominous title and front-cover description (“Medicine disregarded it … Antibiotics can’t control it …”), Maryn McKenna’s Superbug is packaged as a bio-thriller. In this literary subgenre, encompassing both fiction (The Andromeda Strain) and nonfiction (The Hot Zone, as well as the book under review), the security and predictability of modern civilization are suddenly shattered by the outbreak of an enigmatic infectious disease. We see the terrible truth that our way of life is fragile and tenuous, subject to wild, dark forces. The stories’ heroes—usually doctors and scientists—strive to make sense of the plague and turn back the tide of entropy. At the end of these tales, when order has been restored, we feel a rush from our brush with danger and relief that the chaos has been calmed. But instead of providing the consolation of a happy ending, Superbug warns that the worst is yet to come.
The book’s subject, a bacterium named staphylococcus (staph) aureus, has probably been with humans as long as we have existed. While it often lives innocuously on our skin, staph can cause infections when it enters our bodies through means such as a cut or inhalation. The release of the first antibiotic, penicillin, in 1944, inaugurated an era of effective treatment for previously fatal bacterial maladies such as staph. With the 20th century witnessing its second world war, this miracle cure buoyed the beleaguered myth of progress. A May 1944 cover of Time featured a portrait of penicillin’s discoverer, Sir Alexander Fleming, and declared “His penicillin will save more lives than war can spend.”
But soon after penicillin came into use, strains of staph resistant to the antibiotic began to appear. A June 16, 1953 article in the New York Times entitled “Antibiotic Effect Feared on Decline” reflected scientists’ growing concern. In 1960, after years of intensive research, a promising new antibiotic named methicillin was introduced in the United States. Pharmaceutical chemists had specially designed it to foil staph’s mechanism for resisting penicillin. The creators of this breakthrough germ-killer were confident that if resistance to it were to occur at all, it would be far in the future. So it came as a rotten surprise when a 1961 issue of the British Medical Journal reported three cases of staph infections unresponsive to methicillin. Thereafter, all strains of staph resistant to methicillin and its antibiotic descendants were termed methicillin-resistant staph aureus (MRSA).
Superbug describes how in the decades since its first appearance, MRSA has become a worsening problem in hospitals around the world. Catheters and surgical incisions provide the bacterium with ports of entry. Once inside the frail, sick bodies of hospitalized patients, MRSA grows with little resistance. Gathering ill individuals together, hospitals act as Petri dishes, with workers often unwittingly spreading the bug from patient to patient. For instance, a 1980 MRSA outbreak in a Seattle hospital that killed 17 patients and sickened many more was ultimately traced to one nurse who was colonized with the bacterium in her ears, nose, armpits, and groin.
The menace of hospital-acquired MRSA is part of a larger, important story in American medicine that has largely been ignored in the ongoing health care debate. In 1999, the Institute of Medicine’s landmark study To Err is Human concluded that from 44,000 to 98,000 people die each year as a result of preventable medical errors—the equivalent of a 747 plane crashing every other day. The transmission of infections such MRSA to hospitalized patients was cited as one of the chief causes of this avertable loss of life.
Superbug reports that in 1990s, a new strain of MRSA appeared. The pathogen had hitherto been exclusively a hospital phenomenon. But just over a decade ago, an emerging version of MRSA began attacking previously healthy people who had not been recently hospitalized. The book tells the tragic tales of individuals with innocent-appearing respiratory or skin infections who overnight became deathly ill from what was later discovered to be MRSA. In one awful story, a young couple in the Hyde Park area of Chicago took their 17-month-old son to the emergency room (ER) because of a fever. Shortly after they arrived home from the ER with some antibiotics and reassurance that the boy would be well, his lips became blue and his breathing labored. By the time they returned to the hospital, their toddler’s lungs had been destroyed by pneumonia and he shortly thereafter died of septic shock. What at first appeared to be a simple infection that would respond to first-line antibiotics turned out to be MRSA.
As the MRSA problem worsens (by 2005 causing more annual deaths than AIDS), researchers have identified potential factors contributing to its growth. Superbug shows how some of the sources of the MRSA surge flow from cultural, political, and economic forces. Physicians’ injudicious prescription of antibiotics for viral infections is driven by the demand for an instant germ-killing cure, when all that is really possible and necessary is some rest and cough medicine. As more Americans enter prison or jail, the overcrowding, suboptimal health care, and poor sanitation often present in these institutions have made them perfect MRSA incubators. Indeed, epidemiologists have calculated that correctional facilities are more potent than hospitals at disseminating the infection into the surrounding community. Finally, there is the effect of industrial livestock production. In the 1950s, cows, chickens, and hogs crowded into feedlots and barns began to routinely be fed small doses of antibiotics as research showed this caused them to grow faster. This liberal use of antibiotics propagates drug-resistant bacteria that the closely confined animals pass to and fro in much the same way that inhabitants of prisons and hospitals do. New strains of MRSA and other antibiotic-resistant pathogens are thus created and spread into the human population by means such as flies, wind, and people.
While effectively addressing the issues fueling MRSA’s rise will be difficult, having antibiotics available to treat the infection could pose just as a great of a challenge. Superbug reports that MRSA may be developing resistance against the few antibiotics still able to kill it and pharmaceutical companies are not in a rush to generate new ones. This is because antibiotics are only used for days to weeks, making them less revenue-generating than medicines that treat chronic conditions such as diabetes or hypertension. Moreover, after spending hundreds of millions of dollars developing an antibiotic that works against MRSA, pharmaceutical companies face the very real prospect that an unpredictable mutation will render the new antibiotic ineffective after only a few years.
While the fearful future that Superbug presents is not cause for fleeing to the nearest sterile bubble, the suffering and expense that MRSA causes are real and deserve a wise, robust response. At the same time, despite the triumphal predictions of some futurists, human mastery of nature will never be complete. So even if we are clever and lucky enough to find a silver bullet for MRSA, it will not be long before another superbug emerges in its place, putting human ingenuity and resourcefulness again to the test.
What’s in a Face?
I remember once developing a large sore on my lip and being ashamed to have anybody see my face. As embarrassed as I felt, I took comfort in knowing this mar on my appearance was temporary. So I only got a small taste of what it must be like for people who are disfigured for a longer period of time or even permanently. Why can an alternation in our physical appearance so significantly affect our sense of identity and self worth? In part, we justifiably fear being less loved and valued if we’re no longer attractive. As Daniel Sulmasy writes,
“From childhood, people learn not to pity but to laugh at those who are not beautiful. Later in life, the homely and deformed are passed over in job interviews. They have trouble finding love. No one wants to be seen with them at work or in social circles. The ugly and the deformed have always been among the greatest outcasts in any society, but perhaps never so much before as in our own media-saturated twenty-first century.”
But there is more to it than that. Our appearance, the face we present to others and to ourselves in the mirror, is one of the primary ways that we are identified and known. When you think about a person, an image of his or her face comes to mind. When you want to know who somebody is, you look on Google for a facial image. So when your facial appearance is altered, one of the major ways that you are known is changed.
These considerations came to mind when reading a fascinating article in The Verge about people undergoing facial transplantation. In this procedure, victims of disfiguring injuries, such as severe burns, receive a face harvested from another person who suddenly died. Although individuals undergoing facial transplantation have already experienced a radical change in their appearance, researchers are studying the psychological impact of taking on somebody else’s face.
All of this confers greater significance to the stories in the gospels of Jesus healing people with the skin disease of leprosy. In that time and place, leprosy carried a severe stigma, rendering you “unclean” and banished from the community. In touching and healing leprous persons, Jesus was affirming their dignity and worth, removing their status as outcasts.
Pondering the subject of faces, my thoughts return to my son’s condition of autism and its relationship to early childhood development. We now know that newborn infants show a visual preference for faces over other complex visual stimuli. By 7 months of age they discriminate facial expressions, showing a different electrical brain pattern response to different emotional faces. Children with autism are observed to pay less attention to facial expressions and other social stimuli so that, usually unbeknownst to their parents, less learning is occurring at a crucial developmental period. If you were to observe the therapist that works with my son, you’d notice her emotional enthusiasm and vivid facial expressions. It’s something that seems to be present in most professionals who effectively work with young children. And I now understand why.
Poetry and Prayer
When illness shatters the security and predictability of our lives, when our existence is revealed to be fragile and tenuous, human beings seek to somehow have the world make sense again. Two ways of “reweaving meaning and order into the torn fabric” are poetry and prayer.[1] Here is a poem and a passage on prayer that I find enriching.
The Peace of Wild Things by Wendell Berry
When Despair grows in me
and I wake in the middle of the night at the least sound
in fear of what my life and my children’s lives may be,
I go and lie down where the wood drake
rests in his beauty on the water,
and the great heron feeds. I come into the peace of wild things
who do not tax their lives with forethought
of grief. I come into the presence of still water.
And I feel above me the day-blind stars
waiting with the light. For a time
I rest in the grace of the world, and am free.
From Philip Yancey’s book Prayer
“I became a father, with a daughter and a son. As they slept, I would step into their rooms, make the sign of the cross over them, and pray for their future. A parent has such little control. You have to fall back on to God.
My son has epilepsy. His first grand mal seizure terrified me. We called for an ambulance, and I held him in my arms as my head shook from side to side, stroking his forehead, trying to say calming words while inside I felt the opposite of calm. Consciously I tried to pour my spirit into his, to take on his pain. I doubt I’ve ever felt closer to my son than during that first seizure when I held him—both of us so helpless, so afraid.
Prayer for me has become a form of blessing. . . Bless you, child, I would say over my daughter’s crib. Bless you, I would say while holding my convulsing son. I want to be a conduit of God’s blessing to others. I want to feel that blessing for myself, in prayer.
Sometimes I rest, relaxed, in God’s love. Sometimes I thrash and tremble, like my son during a seizure.”[2]
Dementia and the Goals of Medicine
Here is a review I wrote on Making Rounds with Oscar, a book that opened my eyes to the experience of people living with dementia.
In a 2007 issue of the New England Journal of Medicine, amid the usual fare of the latest and greatest in biomedical research, there appeared a short piece about a cat named Oscar. Living as a pet in a nursing home dementia unit, Oscar demonstrated an uncanny ability to predict which of its residents were about to die. The furry creature’s presence at a person’s beside invariably signaled that life’s end was near. The story generated a good deal of interest, earning the feline fifteen minutes of fame. Now, years later, a book entitled Making Rounds with Oscar chronicles a doctor’s discovery of the animal’s special gift.
The author, David Dosa, is a geriatrician at the Steere House Nursing Center in Rhode Island where Oscar lives. He begins the book by explaining why he made the unusual choice to specialize in care for the elderly. I call his career decision unusual because gerontology remains among the least popular fields of practice for medical students to enter. Geriatric fellowship training programs at even the most prestigious institutions are sometimes unable to find willing candidates. Why is this the case at a time when our aging population needs more practitioners equipped to care for its elderly members? In a fee-for-service system that pays physicians for performing procedures and seeing a high volume of patients, the time-intensive nature of geriatric medicine makes it a specialty with some of the lowest reimbursement for the greatest amount of work. And while many young people enter medicine hoping to someday be the celebrated bearers of miracle cures, geriatric care focuses on helping individuals adapt to the inevitable frailties and limitations that come with age.
But Dosa does not lament or even mention what he has foregone in money, power, and prestige. The fulfillment he derives from his vocation among the elderly does not seem to leave much room for feelings of martyrdom or envy. It is a fulfillment he says comes from bearing witness to the stories of his patients as they live the last of their days. These stories form the heart of the book and Oscar’s tale serves as an ideal vehicle for sharing them.
When a trustworthy nurse at the Steere House tells Dosa about the cat’s extraordinary talent, he is at first skeptical and sets about investigating the matter. One by one, he interviews the families of the patients Oscar accompanied in their final hours. Since all of them suffered from dementia, a revealing portrait of this devastating illness emerges. Dementia is characterized by deterioration in cognition, resulting in behavioral problems and difficulty performing the basic activities of daily life. Alzheimer’s, defined by the accumulation of certain proteins in the brain, is the most common form of dementia, accounting for 60 to 70 percent of cases. Dr. Dosa’s clinical expertise and the poignant narratives of patients and families dealing with this disease combine to make the book a valuable educational resource. In fact, the afterword contains some explicit guidance for those doing the admirable and arduous work of caring for people with intellectual disabilities.
But beyond being useful, Making Rounds with Oscar’s depiction of dementia speaks profoundly to the nature of personhood and the practice of modern medicine. Since at least the time of John Locke, philosophers have reflected upon the idea of personal identity. As an individual changes, what remains constant and defining, allowing him or her to be considered to be the same person over time? For the loved one of somebody with dementia, this can be much more than a matter for idle speculation. When the essential qualities and traits of your parent, spouse, or sibling are no longer present in their diminished state, who is it exactly that you are caring for and relating to? The son of one Steere House patient implicitly responds to this question by remarking “I said good-bye to my mother a long time ago. Now I’ve just fallen in love with this little lady!” Other characters in the book do not share such a sanguine approach to what has been lost. When one day, after sixty-three years together, the wife of a man named Frank Rubenstein no longer recognizes him, he never again returns to the nursing home to see her. Though Rubenstein continues to call daily to check on his wife’s status, he cannot bear to see the fear and suspicion on her face when she encounters him as a stranger entering her room. But even as dementia surrounds a self in isolating darkness, creative acts of engagement can sometimes reconnect us, if only briefly, to the person we once knew. For example, Jean Ferretti, the wife of the pioneering musical composer and Steere House patient Ercolino Ferretti, reports to Dosa that “one of the things I found most interesting about my husband’s disease was that even toward the end of his life he responded to music. Here was this man who could no longer do much of anything. Sometimes he would get agitated. If you put on a jazz record, though, he would just sit there contentedly for hours.” As dementia transforms these individuals’ relationships with their affected loved ones, what does not and cannot change are the covenantal bonds they share with them. No matter how faintly these victims of dementia resemble who they once were, to their family they are still father, mother, husband, wife, sister, and brother.
Closely related to the issue of personal identity is the question of what makes human beings valuable and worthy of care. The residents of the Steere House dementia unit have lost capacities that many people see as essential for a meaningful life. In their impaired state, it seems that they can no longer contribute anything to society. Given these realities, is the tremendous work required to care for them warranted? Based on a certain utilitarian calculus, the answer to this question is no. But if all people are considered to have intrinsic dignity and worth, then a radically different response is demanded. For instance, in the Christian tradition, the Gospel is most manifest when people embody Jesus’ special love for those who can offer nothing in return.
But we must not confuse our sacred call to care for people with dementia with the automatic, reflexive use of all available technologies in efforts to extend their lives. When a medical intervention is more likely to be burdensome than beneficial, the more loving course of action may be to aim for comfort rather than the prolongation of life at all costs. This is illustrated in a heartrending story about a frail, debilitated Steere House resident named Saul Strahan. When Strahan develops a severe infection, Dosa discusses his grave condition with Strahan’s daughter and recommends against sending her father to the hospital’s intensive care unit (ICU) for aggressive and likely futile treatment. He suggests instead that Strahan remain in the familiar surroundings of the nursing home with a focus on providing him a peaceful death as the infection worsens. Viewing this approach as giving up on her dad, she insists that “everything be done,” even if there is very little chance of his recovery. Dosa later finds a Strahan in the ICU on life support–a breathing tube down his throat, a central line in his neck, and a dialysis machine at his bedside about to be used as a substitute for his failing kidneys. Dosa is saddened, but not surprised to soon thereafter learn of his patient’s death.
All available medical technology had been utilized on this man’ behalf. But amid the heroic efforts to save his life, nobody was really present with him during his lonely transition into the unknown. This tragic irony reflects many patients’ and practitioners’ conflicted experience of contemporary medicine. The past century witnessed the emergence of biomedical innovations our ancestors could have scarcely imagined. We can administer vaccines and antibiotics to prevent and eliminate previously fatal infections. We can replace insulin and other vital hormones when our bodies’ production of them is insufficient. We can open obstructed arteries during heart attacks and strokes, halting lethal damage to our hearts and brains. We can cure certain cancers with surgery, radiation, and chemotherapy. This growing, seemingly limitless capacity to triumph over afflictions before which humans had hitherto been helpless has radically altered our expectations of health care. For the first twenty-three centuries of Western medical practice (dating from the time of Hippocrates), clinicians’ primary role was to accompany and guide their patients through the experience of illness. In contrast, now that efficacious interventions are available, achieving desirable results is what matters. Yet positive outcomes are not always possible. Indeed, despite modern medicine’s numerous successes, death is the still the ultimate outcome for us all. And as the focus has turned to most efficiently fixing patients’ problems, the healing, pastoral aspect of care that once constituted the heart of medicine has been neglected, to the frustration of patients and physicians alike. The simple example of a cat lying lovingly at a dying person’s side calls health care practitioners back to the sacred role of being a compassionate presence.
Aging with Humor
One of the privileges of my work is observing how people respond to getting older and entering a different season of life. It is, for instance, interesting to see how men respond to retirement. Some ease effortlessly into the slower, less stressful pace of life after work. Their days are filled with enriching activities like golfing, traveling, playing with grandchildren, volunteering, reading, and photography—to the point that some tell me they can’t comprehend how they ever had time to work. In contrast, for other men retirement presents an existential crisis. Their identity and purpose had been so tied to their work that they struggle to identity who they are and what they are living for.
Another challenge of aging is the physical changes and frailties it brings. Some people fatalistically declare that getting older means their body will fall apart. Others optimistically believe that with the right behavior, they can retain most of the capacities of their youth. Still others summon the gift of humor. In his new book, the comedian Billy Crystal provides some funny reflections on his own aging journey. I thought I’d share a few passages that made me laugh.
“During the past year I saw my dermatologist more than I saw my grandkids. Things started to grow on me where they shouldn’t. I don’t shower anymore; I’m sandblasted twice a week. I’m always at the dermatologist’s. He keeps picking at me; I’m like his own personal honey-baked ham.”
“I tell people I sleep like a baby; I’m up every 2 hours. And it’s so lonely when you can’t sleep and your spouse can. Sometimes when I wake up, I fake a nightmare, just so I have someone to talk to. ‘Don’t—no, no put the gun down, no!’ ‘Honey, you okay?’ ‘Yeah, I’m okay, it was just a bad dream. You want to play cards?’ “
“The drug companies make the commercials for their medicines look so beautiful. These people have real problems and in thirty seconds it’s all solved, there are butterflies and bike rides and people walking their puppies, whatever they have is cured, their prostates are shrinking, their bones aren’t brittle, their hairlines are back, and I’m filled with hope. Then right at the end of the commercial that voice comes on and quickly says. . . .May cause lack of appetite, dizziness, nervousness, psychotic episodes, blurred vision, stuttering, skipping and jumping, barking at the moon, bile backup , diarrhea, and impotence.”
So often patients tell me how young I look, but I marvel at how wrinkled and discolored my skin is compared to that of my two little boys. It reminds me that I too am aging and will someday experience the blessings and challenges of being old.
What is Palliative Care?
After finishing medical school and my residency in internal medicine, I undertook an additional year of training in a field called palliative care. Patients who notice my background sometimes ask me what exactly palliative care means. It’s really a simple concept. Palliative care is helping people with a serious illness have the best possible quality of life. It’s enabling sick patients to make the most of the time they have left to live. The term palliative care comes from the latin word palliare which means to cloak or support.
Helping people have the best quality of life possible is a simple idea, but how do you do it? I will address that point, but first I want to distinguish palliative care from hospice since the two terms are often understandably confused. Hospice provides care for terminally ill patients and their families. Hospice care is often provided in a person’s home, but it can also be utilized in a facility such as a nursing home or assisted living. Hospice incorporates a team of healthcare professionals, from doctors and nurses, to social workers, health aids, and chaplains. It is a benefit under Medicare and many insurance plans. Palliative care is a broad concept that encompasses hospice. At some point, a person with an illness will move closer to death and hospice may helpful for allowing them to have the best possible quality of life. But helping a person with an illness feel their best doesn’t have to wait until he or she is dying. It can start as soon as they are diagnosed and while they are receiving treatment to cure their illness or prolong their life.
Palliative care’s roots can be traced to Dame Cecily Saunders’ work in Great Britain in the 1960s developing the modern hospice movement. In the 1970s, an oncologist named Dr. Balfour Mount in Canada incorporated the principles of hospice into care even before people approached the end of life. He coined the term palliative care. Over time, more and more hospitals have developed palliative care teams and recently formal specialized training programs in palliative care have been developed.
So how do we provide palliative care? What are the ways that we can enable a person with a serious illness to enjoy the best possible quality of life? I’m going to discuss three essential components of palliative care: Identifying Goals of Care, Controlling Symptoms and Caring for the Whole Person.
Quite often when caring for somebody with an illness the goal simply becomes treating the illness. So if somebody has lung cancer the goal is to eliminate or slow down the cancer. Or if somebody has congestive heart failure, the goal is to have the heart pump effectively for as long as possible. But why do we treat the illness in the first place? Treating the illness is a means to helping the person be their best and make the most of their life. Treating the illness should not be the primary goal.
I want to provide some examples of identifying goals of care. The first centers upon a person I’ll call Mary. Rather than being an exact story of a particular case, Mary’s tale is a composite of some situations I’ve encountered over the years of my training and practice. Mary was a 88 year old frail woman with many different chronic illnesses. She developed severe pneumonia for which she was hospitalized. In the hospital, she became very weak, so that she had to discharged from the hospital to a rehabilitation facility to try to regain some strength. Soon I received a note from the hospital stating that she had been admitted again for another episode of pneumonia. During this hospitalization, she suffered a stroke. When I went to visit her in the hospital, she was scheduled to have a feeding tube inserted since the stroke had left her with difficulty swallowing. I sat with her family and we discussed what was right for Mary. We first exchanged information. I asked them their understanding of what was going on with her body. I then explained that the feeding tube would not prevent her aspirating her saliva. In addition, the stroke had left her confused and if a feeding tube was inserted, Mary would likely try to pull it out. She might have to be restrained or receive heavy sedative medications to keep the feeding tube in. Since Mary was too confused to make any decisions, I asked her family, what would have been her goals of care in this situation. After reflecting upon this, they felt certain she would not have wanted the tube inserted. She would have most valued her quality of life. So we did not have the tube inserted and she was sent home with the support of hospice. When I received a note from Mary’s daughter later telling me she had died, they were grateful they had not put her through another procedure and that she had been able to spend her final days in the comfort and familiarity of home rather than at the hospital.
Another example of identifying goals of care is Amy Berman. She is a nurse who has become a spokesperson for palliative care. When she was diagnosed with advanced, incurable breast cancer she was first advised to have a mascectomy and intensive chemotherapy and radiation. Getting a second opinion from a different oncologist and a palliative care physician, she decided on a different course. In order to be able to feel well enough to enjoy the time she had left to live, she decided on a gentler, less toxic chemotherapy regimen and high quality symptom control. My patient Mary and Amy Berman benefited because instead of just going with the flow, there was thought given to what their goals of care were.
Another task of palliative care, another way that we seek to enable people have the best possible quality of life, is through controlling burdensome symptoms. Sometimes in treating illness, especially cancer, burdensome symptoms get neglected. So the cancer may be shrinking, but the person’s pain may be excruciating. Palliative care doctors and nurses work to be very good at treating pain and other symptoms. They also seek to train other health care providers to do this effectively. Some of the common symptoms we treat are pain, nausea, shortness of breath, fatigue, depression, anxiety, delirium, and constipation. There is an art and science to treating each of these symptoms well and doing so can make a tremendous difference to a patient and their loved ones.
The last component of palliative care is treating the whole person. I’d like to ask you to imagine for a moment that you were facing imminent death. What things would allow you to best bear this experience? What could make it as positive and meaningful as possible? In a national survey published in The Journal of the American Medical Association, 340 seriously ill patients were asked to rank 9 attributes of quality of life at the end of their lives. The patients ranked “peace with God” just below “freedom from pain” as the most important attribute of a good death.
This points to the fact that illness is not just something that happens to our bodies. It affects the way we think about ourselves and make sense of the world. It affects our finances. It affects our relationships. Cicelly Saunders’ term for the many ways that an illness affects a person is called “total pain.” Palliative care seeks to provide holistic care by attending to the multiple ways that illness affects a person.
To do this, palliative care uses a team approach. A typical palliative care team includes a physician, nurse, social worker, and a chaplain. They each have skills to address the different aspects of person’s experience of illness.
So what is palliative care? Palliative care is the goal of helping people live as well as possible for as long as possible. It does so by aiding individuals in identifying their goals of care, controlling burdensome symptoms, and caring for the whole person.
Although most of my work as a doctor is in the field of internal medicine, I still have the privilege of practicing from time to time at Hospice Austin’s Christopher House. A gift to the Austin community, Christopher House serves people enrolled in hospice whose symptoms are too severe to be controlled at home. It seeks to honor this sacred time in individuals’ lives by providing a home-like environment for patients and their families.
Electroconvulsive Therapy (ECT)
At the end of medical school, when it was time to choose my specialty, I was torn between psychiatry and internal medicine. Psychiatry seemed most suited to my interests and aptitudes. Focusing on the mind and mental illness bridged my interest in the big questions of human existence and the practice of medicine. On the other hand, it was hard to see how being a psychiatrist would fit with the vision of being a medical missionary that motivated me to become a doctor in the first place. I, therefore, chose to receive the broader training that internal medicine would provide.
As an internist, I manage a variety of health issues from gout and hypertension to diabetes and dementia. But perhaps because of my long-standing interest in psychiatry, treating depression is one of the most absorbing and fulfilling parts of my practice. It provides the chance to hear people’s stories, to encounter the complex interplay between the mind and the body, and to quite often offer a helpful treatment. In fact, my experience is that with regular exercise, therapy, medication, or combination thereof, most people successfully recover from depression in a relatively short amount of time.
Unfortunately, there are some patients with depression in whom these initial treatments don’t work. They require the expertise of a psychiatrist and sometimes the combination of multiple medications. And even with the best efforts of a skilled psychiatrist, certain people with severe depression fail to respond to medications and therapy. In such cases of treatment-resistant depression, the sufferer descends into a more miserable and hopeless place. Lacking the motivation to engage in any activities, they may become bed-bound, so that physical weakness begins to accompany their mental lethargy. And the mental lethargy can become so profound that a previously sharp-witted person comes to appear like somebody with end-stage Alzheimer’s Disease, unable to retain information or put their thoughts together. All the while, friends and family watch impotently as their loved one tragically slips away.
In such situations, a treatment called Electroconvulsive Therapy (ECT) can sometimes be quite effective. The idea of causing somebody to experience seizures by applying electricity to their brain evokes an understandably negative reaction. But before quickly dismissing it as barbaric or inhumane it is important to consider the awful, hopeless situations in which ECT is applied and the transforming results it can provide.
In his book, How We Age, geriatric psychiatrist Marc Agronin presents a case from his practice that provides a good deal of insight into ECT. Over a year’s time, a Cuban man named Leonardo had seen his “once bright, loving mother Rosa turn cold, confused, and compulsively agitated.” She was “full of mental confusion, irritability, anxiety, odors of incontinence, and fits of crying and panic that quickly gave way to screaming, kicking, and flailing at any attempts to redirect or soothe her. “ Agronin describes the “almost violent grief” that overtook Rosa’s husband Alberto as his witnessed his wife’s decline. When Alberto spoke, “his entire body seemed to convulse with each phrase, and he vacillated between expressing devastation over the loss of his partner and exaltation over his enduring love for her. His face would twist and spasm as he coughed and choked on his words of concern: ‘She . . . needs more. . . help. . . now!’ Agronin writes that “I always knew when they arrived for appointments because I could hear Rosa’s yelps grow increasingly louder as they approached the door of my office.” At home, “peaceful hours for Alberto with his wife alternated with crises: She fell; she hit him; she urinated on the living room floor.” When Rosa was ultimately transferred to a nursing home, “every effort to care for her was met with fits of panic and screaming.” Agronin tried to address Rosa’s destructive behavior with medications, but each one he tried had produced intolerable side effects. He writes,
“I tried every psychopharmacologic trick in my bag, to but to no avail. In concert with her internist and neurologist, I ran every possible diagnostic test, hoping that I was missing some hidden organic cause. Nothing revealed itself and nothing worked. Alberto and Leonardo were initially patient with my attempts at treatment, but with time they lost faith. Eventually, I too lost faith in my ability to understand and heal her condition. It would have been easiest to simply call in hospice and wash my hands of the case, but something in me resisted.”
After much discussion with Leondardo and Alberto, Agronin decided to hospitalize Rosa and try ECT. Agronin writes that
“despite many misconceptions about ECT, it is actually one of the safest and most effective treatments for severe depression, even in older individuals. A course of ECT typically involves eight to twelve sessions spaced out over several weeks. During each session the individual is briefly anesthetized and paralyzed with medications and then administered an electric shock to the forehead to induced a seizure. We still have no idea how ECT changes brain chemistry to improve depression and other mood disorders, but its effects are impressive. Nevertheless, it’s usually a treatment of last resort. ECT is used even more rarely to treat agitation associated with dementia, but with Rosa I felt we had run out of choices other than massive doses of sedating medications. . . . Over the course of three weeks Rosa received 8 rounds of ECT. Her memory impairment held steady, and she seemed to tolerate ECT well for the first two weeks, but without response. During the third week, however, Rosa’s storm began to subside as she grew quieter and less frenetic. . . Actually, the treatment worked beyond our wildest expectations, and a completely different woman emerged from the hospital. She was generally calm, pleasant, and cooperative. I could actually have a conversation with her.”
Her husband Alberto and son Leonardo were overjoyed by the change. To them, “Rosa, even in her relatively severe state of cognitive impairment, seemed like a rose. It was as if an exile had returned, changed from the experience and not quite the same person, but good enough.”
The story of the surgeon and author Sherwin Nuland provides another revealing look into ECT. In a fascinating, inspiring TED talk linked here Nuland describes suffering from a depression so severe and resistant to medication that during his hospitalization, psychiatrists came close to performing a lobotomy. At that point in the 1970s, ECT had fallen out of favor, and it was only because a resident-in-training advocated for its use in Nuland’s case that he received it. As Nuland shares in his lecture, ECT worked and he was able to ultimately go back to being a productive surgeon and later a writer who won the National Book Award. I highly recommend watching the video.
Opening Ourselves to Others’ Stories
In her essay, Uncovering the Ethics of Suffering, Maj-Britt Raholm applies Hans-Georg Gadamer’s hermeneutical approach to the health care professional’s task of ethically responding to suffering. Gadamer pointed out that humans are situated within traditions formed by family, society, and state. The prejudices or traditions in which we are thrown are the means through which we encounter the world. They constitute the “historically effected consciousness” with which we live. As Raholm writes, “What we hear depends on the kind of questions we ask from our vantage point in history.” Each individual has a unique horizon, which Gadamer defines as “the range of vision that includes everything that can be seen from a particular vantage point.”
“A fusion of horizons” (Horizontverschmelzung) occurs “when our horizon of historical meanings and assumptions fuses with the horizon within which the narrative is placed.” Raholm applies the idea of Horizontverschmelzung to the clinician’s work of understanding their patients’ stories. Health care professionals encounter patients through certain orientating preconceptions or prejudices. Indeed, as Gadamer would remind us, these preconceptions are a necessary port of entry. They help form the reason that the doctor or nurse attends to the patient in the first place. But to understand their patient’s situation, health care practitioners must allow their preconceptions to be challenged, humbly opening themselves to realities they might not expect or anticipate.
Geriatric psychiatrist Marc Agronin illustrates this process in a story from his book How We Age. He describes meeting a ninety-three year woman shortly after the death of her husband of seventy-three years. Agronin writes, “I was overwhelmed by the thought of her loss and wanted to offer some words of comfort. I leaned in close and spoke, ‘I’m so sorry. What has it been like for you losing your husband after so many years of marriage?’ She paused for a moment and then replied, ‘Heaven.’ I flinched for a moment, hoping that I had misheard her. Seeing my bewilderment and understanding immediately the irony of the response, she smiled at me and proceeded to describe how she had endured decades in an unhappy marriage, with a gruff, verbally abusive man. . . In my misguided empathy, I had committed what William James described as the psychologist’s fallacy—assuming incorrectly to know what someone else is experiencing.” Agronin approached his patient with certain preconceptions about what she must be feeling as a new widow. His presumption that she would be sorrowful served as a useful initial guide for their interaction. But Agronin listened openly enough to have his prejudice challenged and replaced by the different reality he received.
Sharing Bad News
My wife recently read me her journal entry from the day our younger son turned two years old. She had written quizzically that he had still not spoken any words despite a good deal of speech therapy. For months previous to that birthday, he had also been engaging in repetitive, obsessive behaviors. He walked circuits around the couch with total concentration, oblivious to the rest of his surroundings. If you were in his way or tried to engage him in another activity, he became upset and screamed for what seemed like an endless amount of time. In fact, interacting with him began to appear impossible. The beautiful boy we adored shrank more and more into his own isolated, small world. It was as if somebody was taking him away from us.
I remember when another person raised the idea that he might have autism. At first, it did not seem like this condition could apply to our boy. My image of autism was a child who could not be affectionate, who rocked uncontrollably. But our little guy did not shrink away from hugs and did not perform any unusual activities with his body.
Still, something was clearly wrong. When he was two and a half years old, we were able to get him an appointment with a pediatric neurologist. I wondered if the doctor would be able to make much sense of his behavior in just one appointment. Shortly after the physician entered the exam room, our older son began trying to take over the appointment with disruptive behavior and I took him out to the car to find a toy to distract him. When I returned to the room and asked my wife what I’d missed she appeared shell-shocked. She mumbled “autism” and when I looked to the neurologist he concurred confidently that this was the diagnosis.
My immediate question was what his future would hold. Would he ever be ever able to live independently, to take care of himself? The doctor told us it was too early to tell. We were given a referral to an autism center and scheduled some blood tests and a brain MRI. And then we left. Completely numb. I went back to work, seeing my patients scheduled for the afternoon and visiting somebody in the hospital I sent to the emergency room that morning.
I try to remember how I felt that day when I deliver bad news to a patient. There is vast divide between the physician sharing a hard reality and the person receiving it. As much as the doctor works to imagine what it must be like, he or she is not the one whose life is changing. The physician moves on to the next patient, while the patient now lives in a new world.